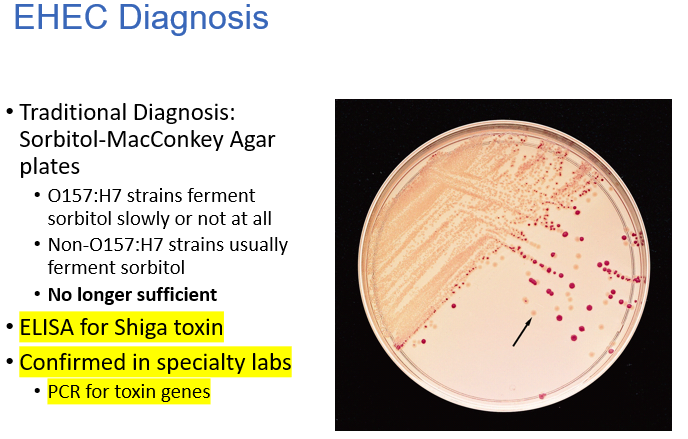

The Enterobacteriaceae are what kinds of bacteria? (GP/GN, areobic/anaerobic)?
Where do these bugs live and how do they get their energy?
Gram-negative facultative anaerobes
Live in gut
Ferment sugars
What do the following antigens represent in serotyping of E.coli?
O antigen
H antigen
K antigen
O antigen – repeating carbohydrate side chains of LPS
H - flagellar antigen (think about the girl in the Sketchy video who had the red hair ties to represent flagella - H (hair) = flagella (red hair tie)
K or capsular antigen – carbohydrate side chains that are removed by heat

Name the types of diarrheagenic E. coli (e.g. EAEC)
Enterotoxigenic (ETEC)
Enteropathogenic (EPEC)
Enterohemorrhagic (EHEC) and other Shiga toxin producing (STEC)
Enteroaggregative (EAEC)
What are the types of extraintestinal E. coli?
Uropathogenic (UPEC) (recall from Sketchy that E.coli is actually the most common cause of UTI)
Strains associated with neonatal meningitis (MAEC) (also remember that baby reaching for the milkshake or whatever in the Sketchy video)
E.coli’s virulence factors are encoded on mobile genetic elements. Name them
Plasmids
Bacteriophages
Pathogenicity islands
Transposons
The main manifestation of infection with ETEC (enterotoxigenic e.coli) is acute onset of ___
ETEC is the leading cause of ___
Traveler’s diarrhea
Watery diarrhea: Rarely fatal but can be as severe as cholera
mild in adults and short duration (less than 5 days)
ETEC infection is typically acquired by ___
ETEC virulence factors include a heat-labile enterotoxin, ___ and ___, all encoded on a virulence plasmid
Ingestion of contaminated food or water
**note that you need a lot to cause disease**
Plasmid-encoded virulence factors:
Heat-labile enterotoxin (remember that this causes cAMP increase)
Heat-stable enterotoxin (remember that this is ass’d with increased cGMP)
Colonization Factor Antigens (pili / fimbriae) - important for adherence
The Heat-labile enterotoxin in E. coli is similar to cholera toxin and has __ A subunit(s) and __ B subunit(s)
This toxin works to increase __ levels which leads to opening of the CFTR channel and increased __ secretion
The Heat-labile enterotoxin in E. coli is similar to cholera toxin and has 1 A subunit(s) and 5 B subunit(s)
After the subunits get internalized, the toxin works to increase cAMP levels which leads to opening of the CFTR channel and increased chloride secretion (the buildup of chloride - and Na+ - is what leads to diarrhea because then water follows wherever the ions go)

What is the function of the heat-stable enterotoxin in E. coli and what’s the mechanism?
The heat stable enterotoxin binds to guanylate cyclase receptor and causes increased cGMP levels (then by some similar downstream signaling pathway you get activation of the CFTR channel and secretion of chloride and the diarrhea thereof)

Describe the clinical features of Enteropathogenic E. coli
Watery diarrhea and vomiting; Usually short duration, but can be protracted and deadly
**think of the Sketchy video and imagine a kid coming into the shop and gets a milkshake (reminder that this is E.coli) that makes him vomit - vomiting - and start to pee himself (watery diarrhea)**
The pathogenesis of EPEC can generally be described in two phases: adherence - mediated by plasmid encoded __, and attachment to gut cells via ___ of microvilli
The pathogenesis of EPEC can generally be described in two phases: adherence - mediated by plasmid encoded pilus, and attachment to gut cells via effacing of microvilli
**Bacteria intimately attached to “pedestals” of polymerized actin and other cytoskeletal proteins
Encoded by Type III secretion system on pathogenicity island
Dozens of injected effector proteins disrupt a variety of cellular functions with multiple potential mechanisms of diarrhea**

EPEC virulence factors are encoded on a ___ and include a Type III secretion system and the protein ___ which is necessary for adherence
EPEC virulence factors are encoded on a Type 3 secretion and include a Type III secretion system and the protein intimin which is necessary for adherence
The primary way to get EHEC infection is thru ___, the main resevoir being ___
The primary way to get EHEC infection is thru contaminated food, the main resevoir being cattle
The main factor contriinuting to the pathogenicity of EHEC is ___, which damages intestinal epithelial cells and endothelial cells in the glomerulus
There’s also the LEE pathogenicity island that’s responsible for ___
The main factor contributing to the pathogenicity of EHEC is Shiga toxin, which damages intestinal epithelial cells and endothelial cells in the glomerulus
There’s also the LEE pathogenicity island that’s responsible for producing attaching and effacing lesions

How does Shiga toxin contribute to EHEC virulence?
Basically the protein binds to GB3 that’s present on a variety of cells and depurinates the 28S ribosomal subunit, thereby inhibiting protein synthesis >> cell death
**in the sketchy video, think of the little boy eating the contaminated burger (EHEC) holding his Shiga-gorilla and the gorilla has a sign that says GB3 (the protein that shiga toxn binds to) and a price tag of 28 Sents (Shiga toxin binds and depurinates 28S ribosomal subunit and inhibits protein synthesis)
The clinical presentation of EHEC infection includes water diarrhea, ___ diarrhea, colonic inflammation and ___, and HUS
Cramps, pain
Watery diarrhea; Bloody diarrhea
Inflammation and edema of colon leading to tissue necrosis in severe cases
HUS (hemolytic uremia syndrome)
The diagnostic triad that clues you into hemolytic uremia syndrome includes hemolytic anemia, ___ and ___
___ can affect any organ and lead to ischemic organ infarcts
The diagnostic triad that clues you into hemolytic uremia syndrome includes hemolytic anemia, thrombocytopenia and renal failure
Thrombotic microangiopathy can affect any organ and lead to ischemic organ infarcts
The risk factors for HUS include age, WBC count, ___ and (two types of drugs)
Typical HUS is associated with ___
Atypical HUS is associated with ___
Age (young kids and the elderly)
WBC count
Vomiting
Anti-motility agents
Antibiotics
**note that antibiotics and anti-motility agents are contraindicated in HUS treatment**

How do you Dx EHEC infection?
Dx: usual McConkey agar (see which strains ferment sorbitol or not), ELISA, and PCR for toxin genes
Describe the clinical features of EAEC
Watery diarrhea with mucous +/- blood; intestinal “colic”, growth retardation
The pathogenesis of EAEC is mediated by ___ which help with the formation of biofilm on intestinal epithelial cells
Aggregative adherence mediated by plasmid-encoded fimbriae
Biofilm formation on intestinal epithelial cells
**note that there’s also damage to epithelial cells due to several toxins such as Pet and EAST**
Describe the functions of the Pet and EAST toxins in EAEC
Plasmid-encoded toxin (Pet): Induces exfoliation of cells and elicits fluid secretion
EAST (some strains): Heat-stable toxin related to that of ETEC
**think PETs are always shedding (exfoliation of cells) and they always pee everywhere or drool etc (fluid secretion)**
**EAST is ETEC’s heat-stable toxin cousin from the far east**

___ is one of the two most common causes of meningitis in neonates (the 2nd being Group B Strept)
Describe how this bug causes disease, and state which drug you would use to treat infection with this bug
K1 capsule (homopolymer of sialic acid that is identical to Group B meningococcus capsule): Masks activation of alternative complement pathway
Fimbriae and invasiveness contribute to pathogenesis
3rd generation cephalosporins
What are the clinical indications of Klebsiella infection?
T/F Kleibsiella is always resistant to cephalosporins so you treat with penicillins
Occasional cause of UTI, severe pneumonia, nosocomial infections
Falsehood. Always resistant to penicillins, usually sensitive to cephalosporins


